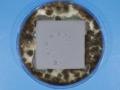

水性硬質ウレタン系塗り床材「タフクリートシリーズ」に新工法を追加
株式会社エービーシー商会

~食品工場や厨房に求められる防カビ性能・耐候性を追加~
建材の開発、製造、輸入、販売を行う(株)エービーシー商会(本社:東京都千代田区、社長:東川 茂樹)は、水性硬質ウレタン樹脂系塗り床材タフクリートシリーズ(MH、SD、FL、NT)において、防カビ性能を付加した工法と、耐候性にすぐれた工法の2種を追加しました。
「タフクリートシリーズ」は、耐衝撃性・耐薬品性・抗菌性・低臭性にすぐれたシームレスな塗り床材です。HACCP Internationalの認証を取得しており(タフクリートNTを除く)、食品工場や厨房、セントラルキッチンなどの高衛生環境において、衛生管理をサポートする床材として幅広く採用されています。今回の新工法の追加により、さらに衛生性・耐候性が強化され、より多様な使用環境に対応可能となりました。
新たに採用された「LR防カビB工法」は、専用の防カビ添加剤を配合。「JIS Z 2911 カビ抵抗性試験 プラスチック製品方法 B」という極めて厳格な評価基準に基づく試験を行い、カビの繁殖抑制が確認されました。温度や湿度の変化が激しい食品製造環境においても、カビの発生を抑制し、清潔な環境の維持に貢献します。
また、「ネオクリートLR工法」は、すぐれた難黄変性と耐候性を備え、変色が起こりにくいため、厨房の床が見えるオープンキッチン型店舗や商業施設など、景観性を重視する空間にも適しています。
当社では、当製品を食品工場をはじめ衛生管理が求められる施設への普及に努めてまいります。
- カビ抵抗性の比較
[画像1:
https://prcdn.freetls.fastly.net/release_image/16820/202/16820-202-43edb97e00944843b317cdf5a066a642-3900x2928.jpg?width=536&quality=85%2C75&format=jpeg&auto=webp&fit=bounds&bg-color=fff ]
タフクリートMH(MH工法)
[画像2:
https://prcdn.freetls.fastly.net/release_image/16820/202/16820-202-ca2b72ad6e93aa6b206e064c2ef3eea4-3900x2928.jpg?width=536&quality=85%2C75&format=jpeg&auto=webp&fit=bounds&bg-color=fff ]
タフクリートMH(MH-LR防カビB工法)
- 工法図(例:タフクリートMHのMH-LR防カビB工法/MH-ネオクリート LR 工法)
[画像3:
https://prcdn.freetls.fastly.net/release_image/16820/202/16820-202-935ac34e7ef8c96a7a5d73edbcf9ef4b-1453x1094.jpg?width=536&quality=85%2C75&format=jpeg&auto=webp&fit=bounds&bg-color=fff ]
厚さ約6mm/9mm
1.欠込目地(10×10mm)
2.下塗
3.上塗+表面調整
- 材工設計価格お問い合わせください。
■製品お問い合わせ先
化成品事業部
TEL:03-3507-7236
このリリースは弊社オフィシャルサイト「ニュースリリース」に掲載しています。
https://www.abc-t.co.jp/news/2025/article/20250530002639.html
■PDFデータ
d16820-202-9c030e762334d9d2a5897c423f58b089.pdf
■会社概要
株式会社エービーシー商会
東京都千代田区永田町2-12-14
https://www.abc-t.co.jp/
・エービーシー商会とは
エービーシー商会は設立以来70年以上、建材のプロフェッショナルとして成長を続けるマーケティングカンパニーです。商社機能とメーカー機能の両方を有し、ブランド価値のある商品ラインナップに技術力を結合して“高品質”をご提供できる点が強みです。商品は身近なランドマークや商業施設、住宅のほか、オフィスビル、公共施設、工場、倉庫、駐車場などに使われ、都市の快適と安全、産業の発展に大きく貢献しています。
プレスリリース提供:PR TIMES

記事提供:PRTimes
![]()